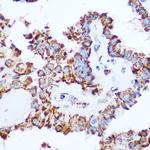
PDHA1 Antibody in Immunohistochemistry (Paraffin) (IHC (P))

Search
Invitrogen
PDHA1 Polyclonal Antibody
{{$productOrderCtrl.translations['antibody.pdp.commerceCard.promotion.promotions']}}
{{$productOrderCtrl.translations['antibody.pdp.commerceCard.promotion.viewpromo']}}
{{$productOrderCtrl.translations['antibody.pdp.commerceCard.promotion.promocode']}}: {{promo.promoCode}} {{promo.promoTitle}} {{promo.promoDescription}}. {{$productOrderCtrl.translations['antibody.pdp.commerceCard.promotion.learnmore']}}

Please note: We are reviewing Western blot images included in the antibody testing data in our catalog, including those provided by third parties. Unless expressly labeled or annotated as “raw-unedited”, Western blot images included in the antibody testing data in our catalog may have been edited, optimized or otherwise adjusted for presentation.
产品信息
PA5-110090
种属反应
宿主/亚型
分类
类型
抗原
偶联物
形式
浓度
规格
纯化类型
保存液
内含物
保存条件
运输条件
RRID
产品详细信息
Immunogen sequence: FANDATFEIK KCDLHRLEEG PPVTTVLTRE DGLKYYRMMQ TVRRMELKAD QLYKQKIIRG FCHLCDGQEA CCVGLEAGIN PTDHLITAYR AHGFTFTRGL SVREILAELT GRKGGCAKGK GGSMHMYAKN FYGGNGIVGA QVPLGAGIAL ACKYNGKDEV CLTLYGDGAA NQGQIFEAYN MAALWKLPCI FICENNRYGM GTSVERAAAS TDYYKRGDFI PGLRVDGMDI LCVREATRFA AAYCRSGKGP ILMELQTYRY HGHSMSDPGV SYRTREEIQE VRSKSDPIML LKDRMVNSNL ASVEELKEID VEVRKEIEDA AQFATADPEP PLEELGYHIY SSDPPFEVRG ANQWIKFKSV S
靶标信息
The pyruvate dehydrogenase (PDH) complex is a nuclear-encoded mitochondrial multienzyme complex that catalyzes the overall conversion of pyruvate to acetyl-CoA and CO(2), and provides the primary link between glycolysis and the tricarboxylic acid (TCA) cycle. The PDH complex is composed of multiple copies of three enzymatic components: pyruvate dehydrogenase (E1), dihydrolipoamide acetyltransferase (E2) and lipoamide dehydrogenase (E3). The E1 enzyme is a heterotetramer of two alpha and two beta subunits. This gene encodes the E1 alpha 1 subunit containing the E1 active site, and plays a key role in the function of the PDH complex. Mutations in this gene are associated with pyruvate dehydrogenase E1-alpha deficiency and X-linked Leigh syndrome. Alternatively spliced transcript variants encoding different isoforms have been found for this gene.
⚠WARNING: This product can expose you to chemicals including mercury, which is known to the State of California to cause birth defects or other reproductive harm. For more information go to www.P65Warnings.ca.gov.
仅用于科研。不用于诊断过程。未经明确授权不得转售。
篇参考文献 (0)
生物信息学
蛋白别名: PDHE1-A type I; pyruvate dehydrogenase; pyruvate dehydrogenase E1 alpha 1; Pyruvate dehydrogenase E1 component subunit alpha, somatic form, mitochondrial; pyruvate dehydrogenase E1alpha subunit
基因别名: Pdha-1; PDHA1; PHE1A
UniProt ID: (Mouse) P35486
Entrez Gene ID: (Rat) 29554, (Mouse) 18597




